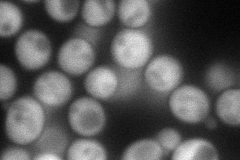
YOL102C
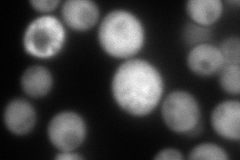
YOL102C
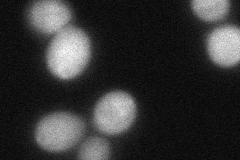
YOL102C

View description
tRNA 2'-phosphotransferase, catalyzes the final step in yeast tRNA splicing: the transfer of the 2'-PO(4) from the splice junction to NAD(+) to form ADP-ribose 1''-2''cyclic phosphate and nicotinamide
Localization:
Intensity:
Fold change:
Significance:
-
C’ GFP library in SD

below threshold19.64 -
N' NOP1pr-GFP in SD
cytosol108.086 -
N' TEF2pr-mCherry in SD
cytosol209.506 -
N' NATIVEpr-GFP in SD

cytosol23.0175 -
N' TEF2pr-VC and Cyto-VN in SD
cytosol63.007 -
C’ GFP library in SD+DTT

cytosol21.661.1No -
C’ GFP library in SD+H2O2

cytosol16.120.82No -
C’ GFP library in Starvation Media

cytosol16.870.85No -
C’ GFP library on the background of Pup2-DaMP

below threshold -
C’ GFP library on the background of CCT mutant

below threshold19.98051.01667No
